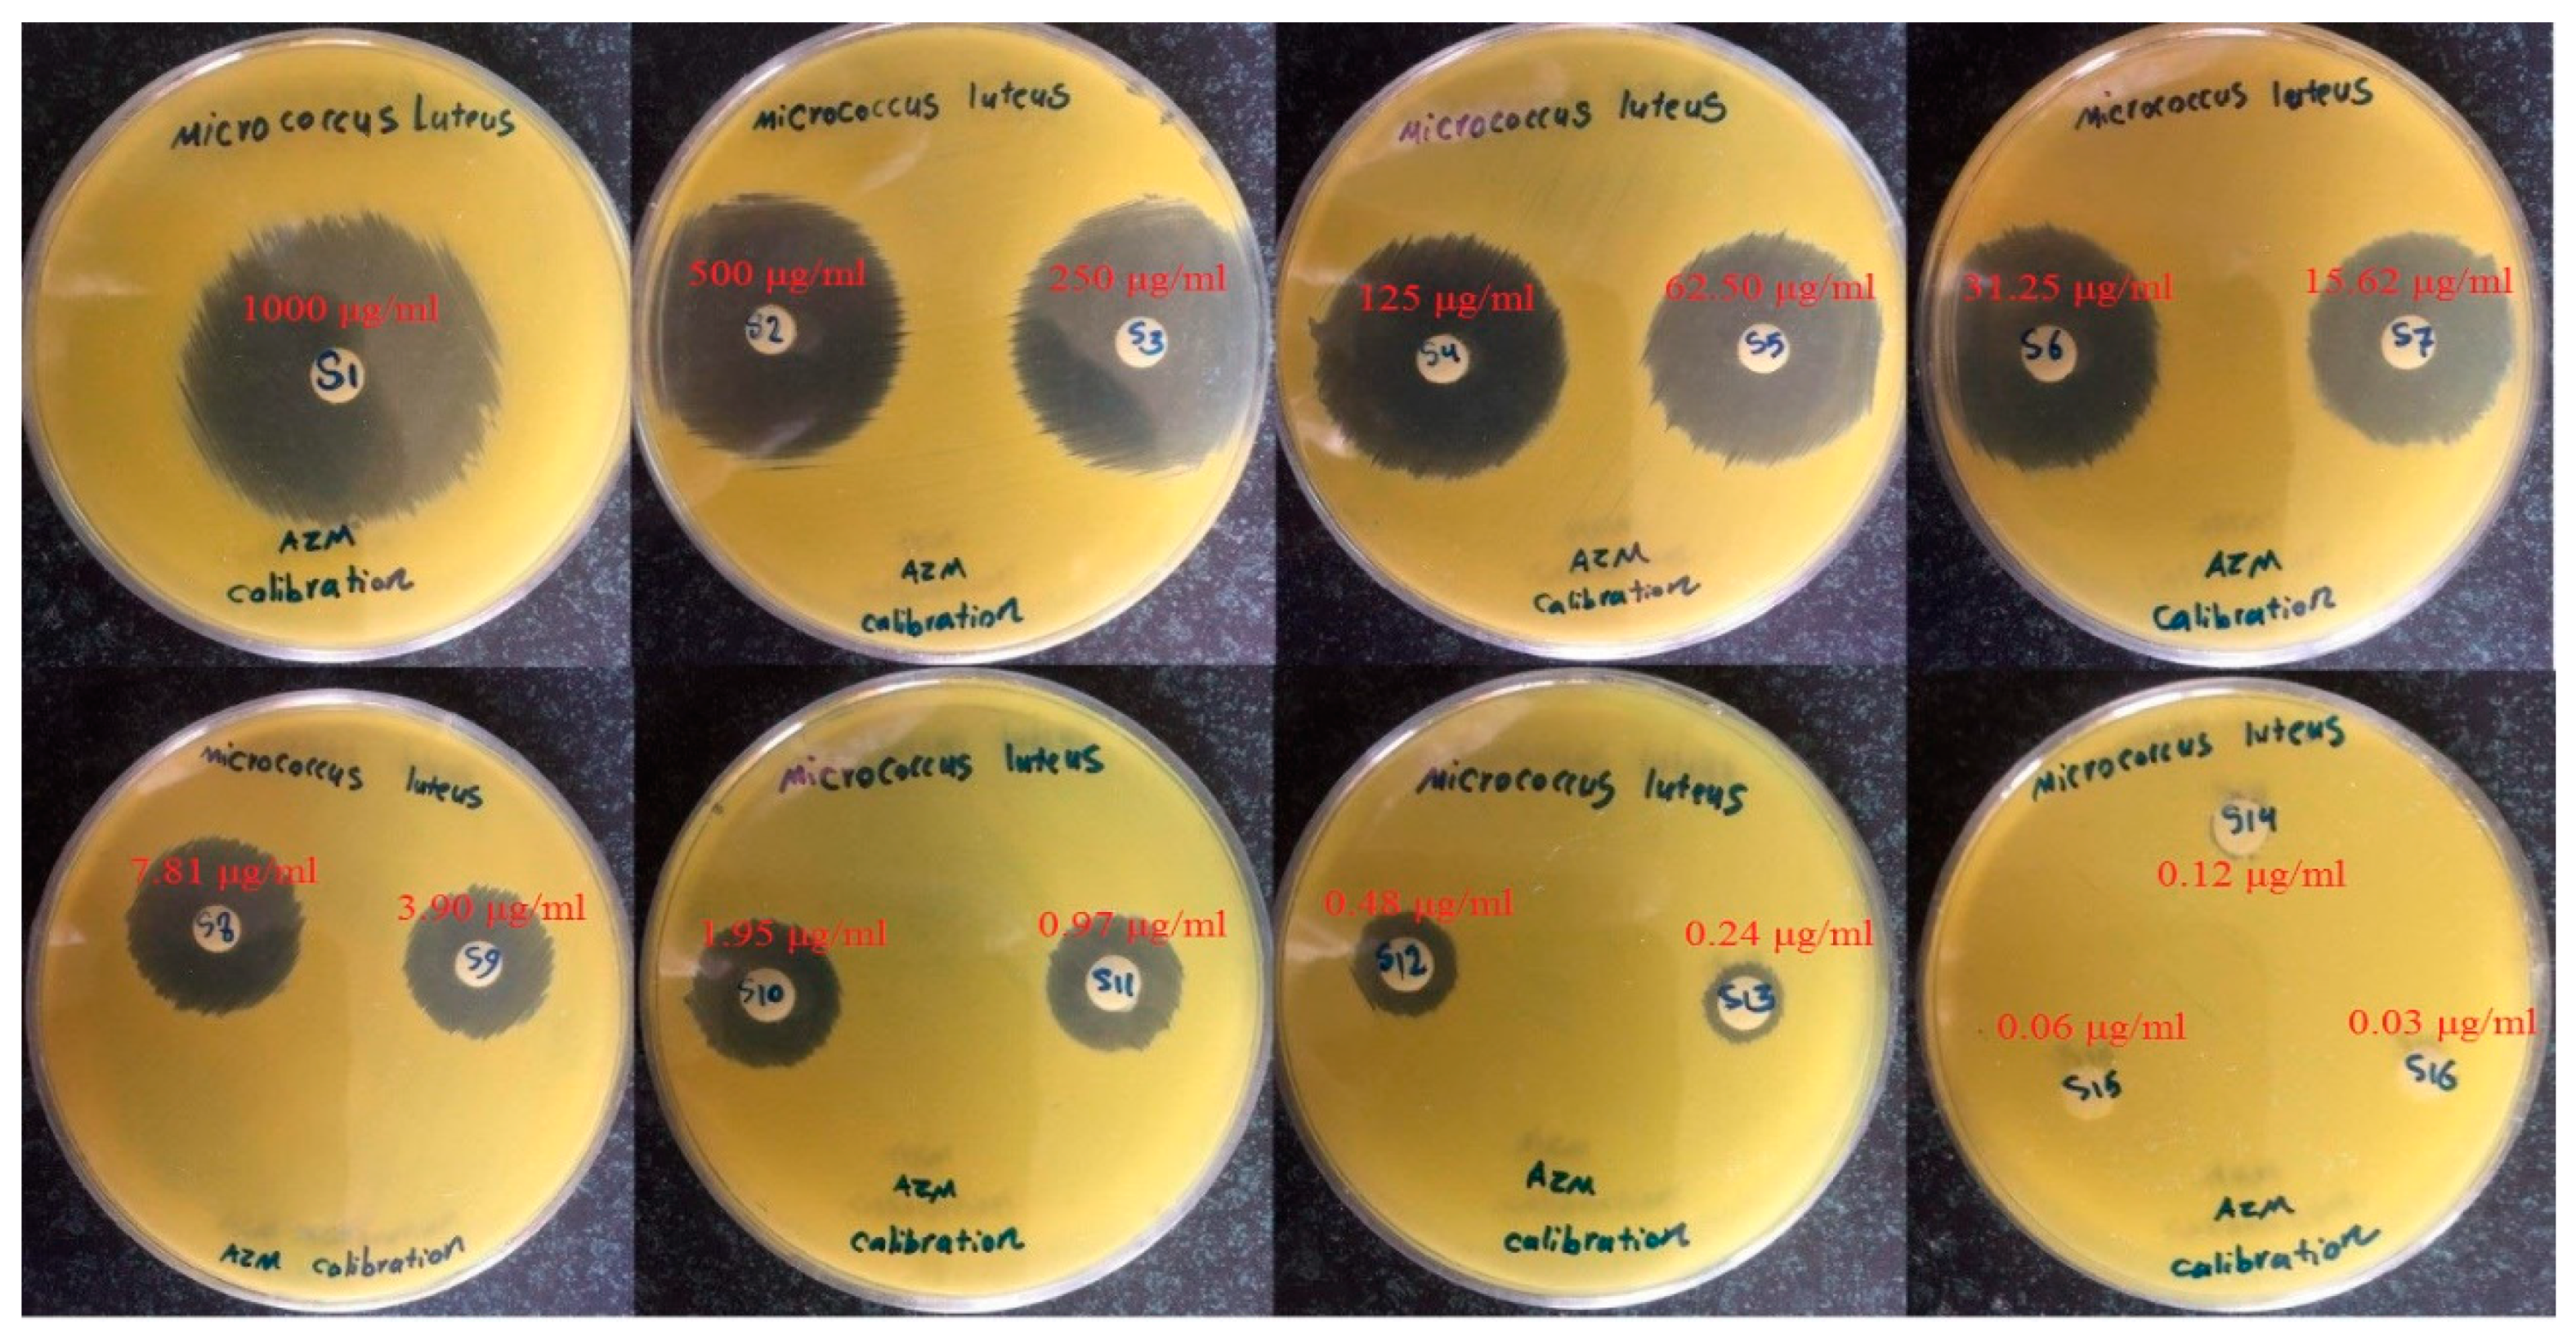
Biomedicines 08 00466 g007 Biomedicines 08 00466 g007
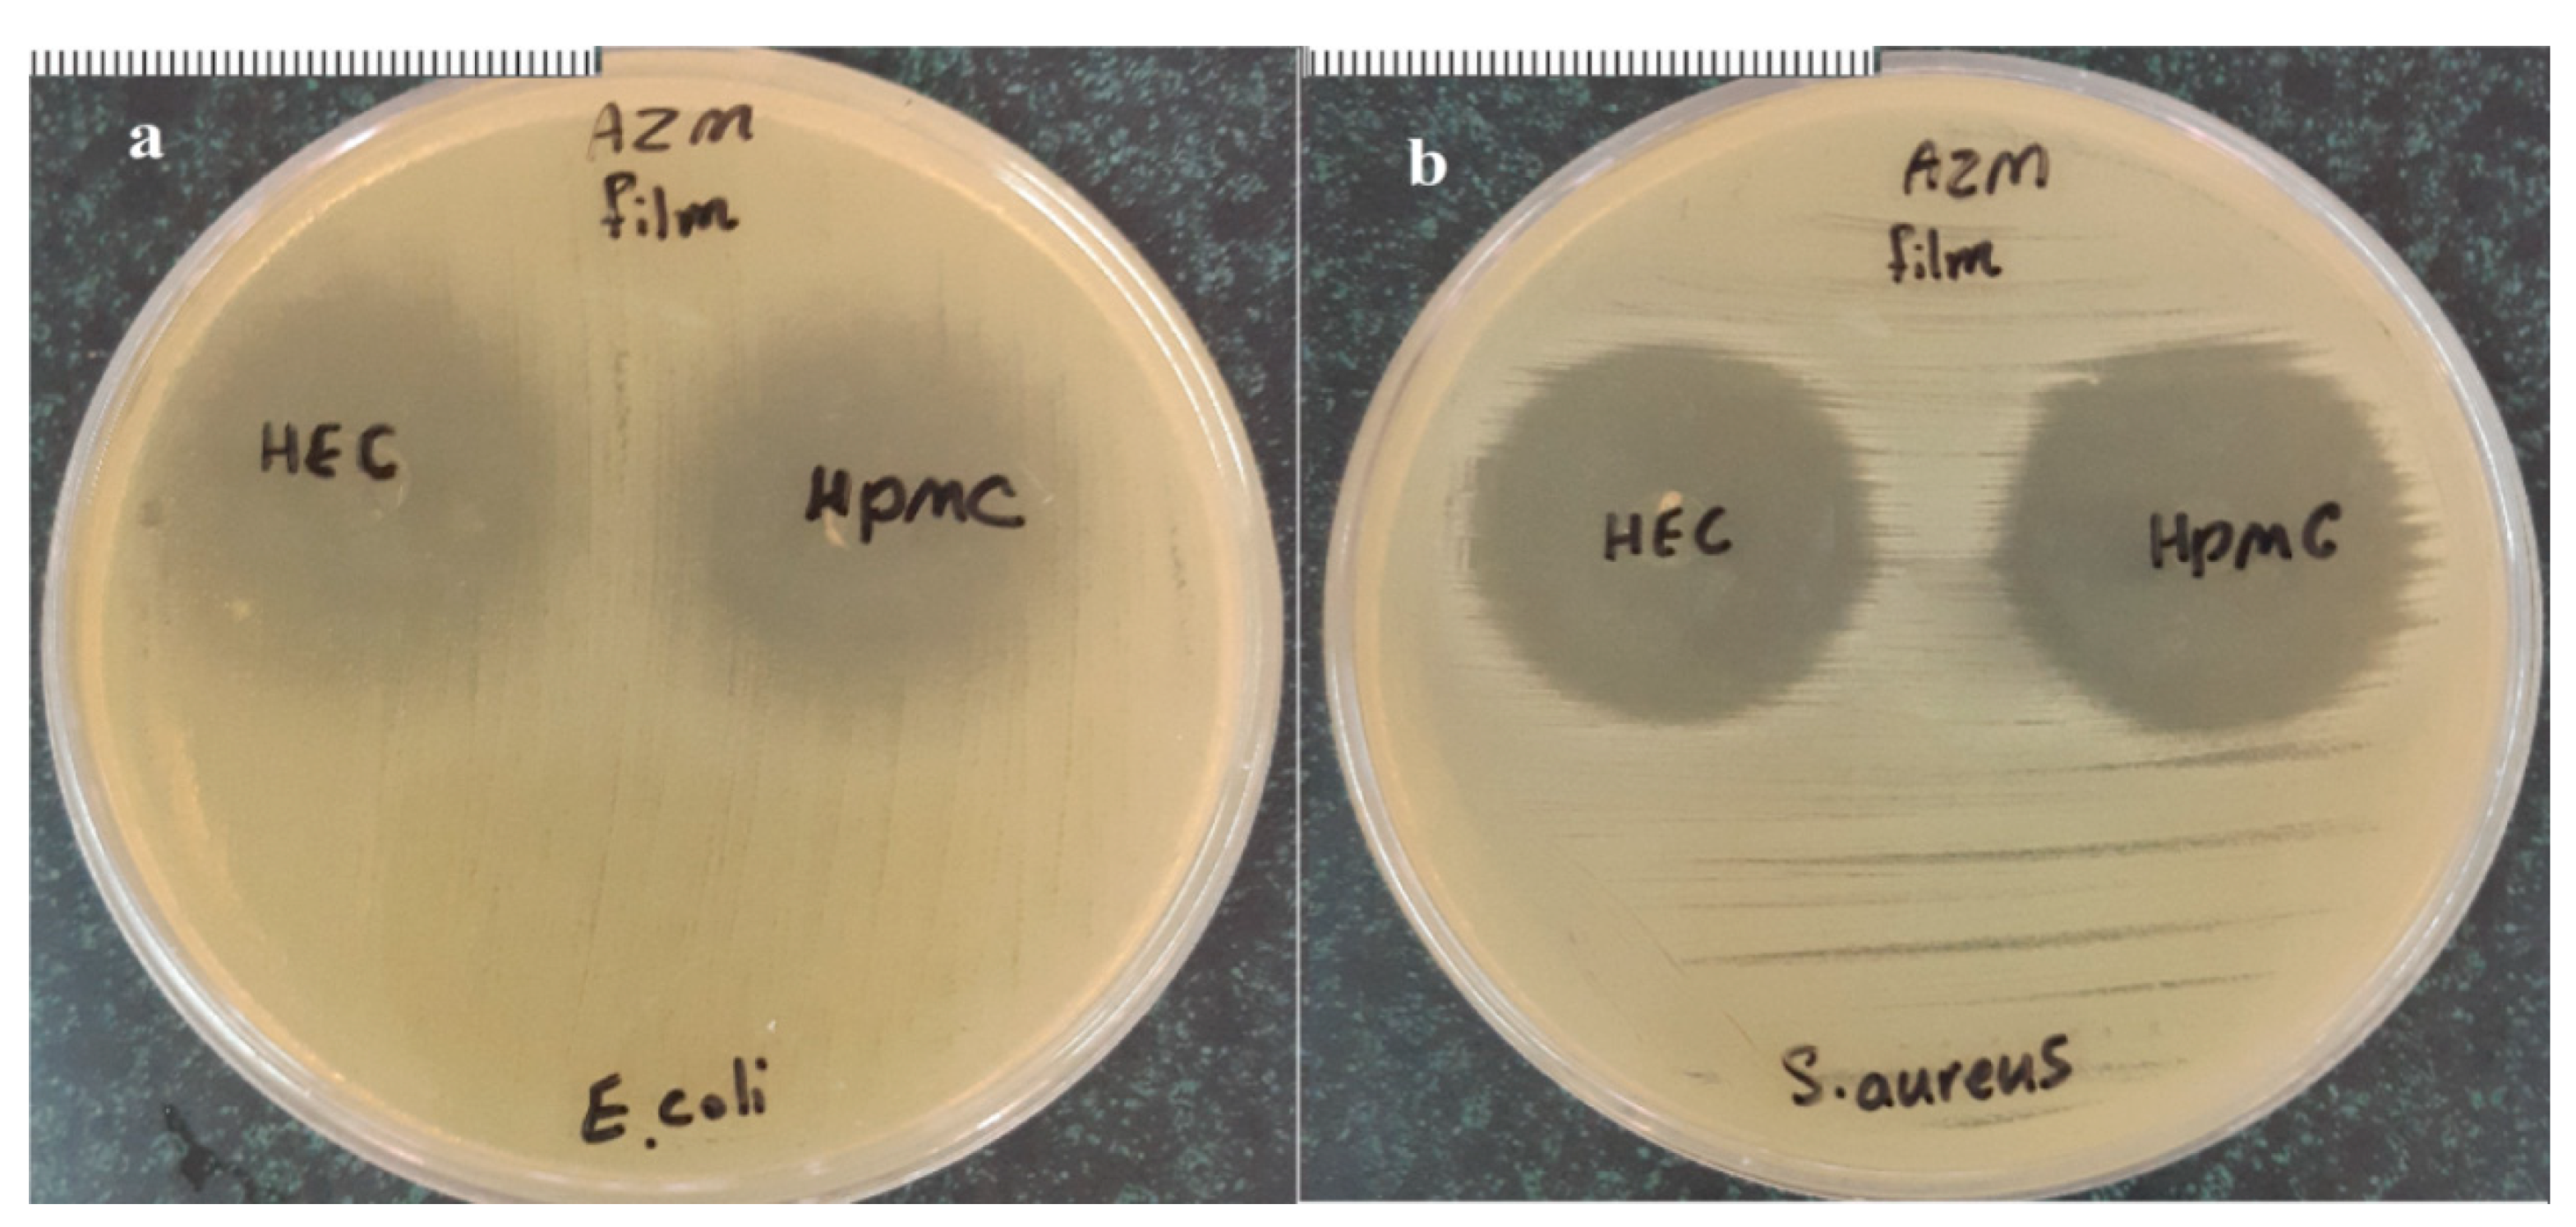
Biomedicines 08 00466 g008 Biomedicines 08 00466 g008

Polymeric Inserts Containing Eudragit® L100 Nanoparticle for Improved Ocular Delivery of Azithromycin
Abstract
1. Introduction
2. Materials and Methods
2.1. Materials
2.2. Preparation of Azithromycin-Eudragit® L100—Nanoparticles (AZM-EUD NPs)
2.3. Characterization of AZM-EUD Nanoparticles
2.3.1. Particle Size and Zeta Potential Analysis
2.3.2. Determination of Entrapment Efficiency of Azithromycin in Nanoparticles
2.3.3. Fourier-Transform Infrared Spectroscopy (FTIR)
2.3.4. In Vitro Cytotoxicity Test
2.4. Preparation of Ocular Inserts
2.5. Characterization of Prepared Ocular Inserts
2.5.1. Inserts Morphology
2.5.2. Thickness Measurement
2.5.3. Folding Endurance
2.5.4. Swelling, Moisture Absorption, and Moisture Loss Studies
2.5.5. Mechanical Strength
2.5.6. Surface pH Determination
2.5.7. Microbiological Assay Test
2.5.8. In Vitro Antimicrobial Efficacy and Sterility Testing
2.5.9. In Vitro Release Studies
2.5.10. Azithromycin Penetration Study
2.5.11. Ocular Irritation Study on Rabbit Eyes
2.5.12. In Vivo Studies
2.6. Statistical Analysis
3. Results and Discussion
3.1. Evaluation of Nanoparticles
3.1.1. Optimization of AZM-EUD NPs
3.1.2. FTIR Analysis
3.1.3. Cytotoxicity Study
3.2. Characterization of Films Containing AZM-Loaded Eudragit® L100 Nanoparticles
3.2.1. Morphological Characterization
3.2.2. Microbiological Assay Test
3.2.3. Sterility and In Vitro Antimicrobial Efficacy Test
3.2.4. In Vitro Studies
3.2.5. Ex-Vivo Trans-Corneal Permeability Study
3.2.6. Ocular Irritation Study on Rabbit Eyes
3.2.7. In Vivo Studies
4. Conclusions
Author Contributions
Funding
Conflicts of Interest
References
- Patel, A.; Cholkar, K.; Agrahari, V.; Mitra, A.K. Ocular drug delivery systems: An overview. World J. Pharmacol. 2013, 2, 47. [Google Scholar] [CrossRef] [PubMed]
- Reimondez-Troitiño, S.; Csaba, N.; Alonso, M.; De La Fuente, M. Nanotherapies for the treatment of ocular diseases. Eur. J. Pharm. Biopharm. 2015, 95, 279–293. [Google Scholar] [CrossRef]
- Jain, K.K. Nanomedicine: Application of nanobiotechnology in medical practice. Med. Princ. Pract. 2008, 17, 89–101. [Google Scholar] [CrossRef]
- Bu, H.-Z.; Gukasyan, H.J.; Goulet, L.; Lou, X.-J.; Xiang, C.; Koudriakova, T. Ocular disposition, pharmacokinetics, efficacy and safety of nanoparticle-formulated ophthalmic drugs. Curr. Drug Metab. 2007, 8, 91–107. [Google Scholar] [CrossRef]
- Rathore, K.; Nema, R. Review on ocular inserts. Int. J. Pharm. Tech. Res. 2009, 1, 164–169. [Google Scholar]
- Ikemoto, K.; Kobayashi, S.; Haranosono, Y.; Kozai, S.; Wada, T.; Tokushige, H.; Kawamura, A. Contribution of anti-inflammatory and anti-virulence effects of azithromycin in the treatment of experimental Staphylococcus aureus keratitis. BMC Ophthalmol. 2020, 20, 1–7. [Google Scholar] [CrossRef] [PubMed]
- Steel, H.C.; Theron, A.J.; Cockeran, R.; Anderson, R.; Feldman, C. Pathogen-and host-directed anti-inflammatory activities of macrolide antibiotics. Mediat. Inflamm. 2012, 2012, 584262. [Google Scholar] [CrossRef]
- Li, D.-Q.; Zhou, N.; Zhang, L.; Ma, P.; Pflugfelder, S.C. Suppressive effects of azithromycin on zymosan-induced production of proinflammatory mediators by human corneal epithelial cells. Investig. Ophthalmol. Vis. Sci. 2010, 51, 5623–5629. [Google Scholar] [CrossRef]
- Sevillano, D.; Alou, L.; Aguilar, L.; Echevarría, O.; Giménez, M.-J.; Prieto, J. Azithromycin iv pharmacodynamic parameters predicting Streptococcus pneumoniae killing in epithelial lining fluid versus serum: An in vitro pharmacodynamic simulation. J. Antimicrob. Chemother. 2006, 57, 1128–1133. [Google Scholar] [CrossRef][Green Version]
- Thakur, R.; Swami, G.; Rahman, M. Development and optimization of controlled release bioerodable anti infective ophthalmic insert. Curr. Drug Deliv. 2014, 11, 2–10. [Google Scholar] [CrossRef] [PubMed]
- Ren, T.; Lin, X.; Zhang, Q.; You, D.; Liu, X.; Tao, X.; Gou, J.; Zhang, Y.; Yin, T.; He, H. Encapsulation of azithromycin ion pair in liposome for enhancing ocular delivery and therapeutic efficacy on dry eye. Mol. Pharm. 2018, 15, 4862–4871. [Google Scholar] [CrossRef] [PubMed]
- Liu, Y.; Lin, X.; Tang, X. Lipid emulsions as a potential delivery system for ocular use of azithromycin. Drug Dev. Ind. Pharm. 2009, 35, 887–896. [Google Scholar] [CrossRef] [PubMed]
- Salimi, A.; Panahi-Bazaz, M.-R.; Panahi-Bazaz, E. A novel microemulsion system for ocular delivery of azithromycin: Design, characterization and ex-vivo rabbit corneal permeability. Jundishapur. J. Nat. Pharm. Prod. 2017, 12, e13938. [Google Scholar] [CrossRef]
- Zhong, M.; Feng, Y.; Liao, H.; Hu, X.; Wan, S.; Zhu, B.; Zhang, M.; Xiong, H.; Zhou, Y.; Zhang, J. Azithromycin cationic non-lecithoid nano/microparticles improve bioavailability and targeting efficiency. Pharm. Res. 2014, 31, 2857–2867. [Google Scholar] [CrossRef]
- Azhdarzadeh, M.; Lotfipour, F.; Zakeri-Milani, P.; Mohammadi, G.; Valizadeh, H. Anti-bacterial performance of azithromycin nanoparticles as colloidal drug delivery system against different gram-negative and gram-positive bacteria. Adv. Pharm. Bull. 2012, 2, 17. [Google Scholar]
- Fessi, H.; Puisieux, F.; Devissaguet, J.P.; Ammoury, N.; Benita, S. Nanocapsule formation by interfacial polymer deposition following solvent displacement. Int. J. Pharm. 1989, 55, R1–R4. [Google Scholar] [CrossRef]
- Mundargi, R.C.; Srirangarajan, S.; Agnihotri, S.A.; Patil, S.A.; Ravindra, S.; Setty, S.B.; Aminabhavi, T.M. Development and evaluation of novel biodegradable microspheres based on poly (d,l-lactide-co-glycolide) and poly (ε-caprolactone) for controlled delivery of doxycycline in the treatment of human periodontal pocket: In vitro and in vivo studies. J. Control. Release 2007, 119, 59–68. [Google Scholar] [CrossRef]
- Aksungur, P.; Demirbilek, M.; Denkbaş, E.B.; Ünlü, N. Comparative evaluation of cyclosporine A/HPβCD-incorporated PLGA nanoparticles for development of effective ocular preparations. J. Microencapsul. 2012, 29, 605–613. [Google Scholar] [CrossRef]
- de Moura, M.R.; Aouada, F.A.; Avena-Bustillos, R.J.; McHugh, T.H.; Krochta, J.M.; Mattoso, L.H. Improved barrier and mechanical properties of novel hydroxypropyl methylcellulose edible films with chitosan/tripolyphosphate nanoparticles. J. Food Eng. 2009, 92, 448–453. [Google Scholar] [CrossRef]
- Mishra, D.; Gilhotra, R. Design and characterization of bioadhesive in-situ gelling ocular inserts of gatifloxacin sesquihydrate. DARU J. Pharm. Sci. 2008, 16, 1–8. [Google Scholar]
- Alagusundaram, M.; Chengaiah, B.; Ramkanth, S.; Parameswari, S.A.; Chetty, C.; Dhachinamoorthi, D. Formulation and evaluation of mucoadhesive buccal films of ranitidine. Int. J. PharmTech Res. 2009, 1, 557–563. [Google Scholar]
- Karunanidhi, A.; Thomas, R.; Van Belkum, A.; Neela, V. In vitro antibacterial and antibiofilm activities of chlorogenic acid against clinical isolates of Stenotrophomonas maltophilia including the trimethoprim/sulfamethoxazole resistant strain. Biomed Res. Int. 2013, 2013, 392058. [Google Scholar] [CrossRef]
- Bharti, S.K.; Kesavan, K. Phase-transition W/O microemulsions for ocular delivery: Evaluation of antibacterial activity in the treatment of bacterial keratitis. Ocul. Immunol. Inflamm. 2017, 25, 463–474. [Google Scholar] [CrossRef] [PubMed]
- Taghe, S.; Mirzaeei, S. Preparation and characterization of novel, mucoadhesive ofloxacin nanoparticles for ocular drug delivery. Braz. J. Pharm. Sci. 2019, 55. [Google Scholar] [CrossRef]
- Chen, H.; Pan, H.; Li, P.; Wang, H.; Wang, X.; Pan, W.; Yuan, Y. The potential use of novel chitosan-coated deformable liposomes in an ocular drug delivery system. Colloids Surf. B 2016, 143, 455–462. [Google Scholar] [CrossRef]
- Sun, X.; Yu, Z.; Cai, Z.; Yu, L.; Lv, Y. Voriconazole composited polyvinyl alcohol/hydroxypropyl-β-cyclodextrin nanofibers for ophthalmic delivery. PLoS ONE 2016, 11, e0167961. [Google Scholar] [CrossRef]
- Mohammadi, G.; Mirzaeei, S.; Taghe, S.; Mohammadi, P. Preparation and Evaluation of Eudragit® L100 Nanoparticles Loaded Impregnated with KT Tromethamine Loaded PVA-HEC Insertions for Ophthalmic Drug Delivery. Adv. Pharm. Bull. 2019, 9, 593. [Google Scholar] [CrossRef]
- Galindo-Rodriguez, S.; Allemann, E.; Fessi, H.; Doelker, E. Physicochemical parameters associated with nanoparticle formation in the salting-out, emulsification-diffusion, and nanoprecipitation methods. Pharm. Res. 2004, 21, 1428–1439. [Google Scholar] [CrossRef]
- Liu, X.; Kaminski, M.D.; Riffle, J.S.; Chen, H.; Torno, M.; Finck, M.R.; Taylor, L.; Rosengart, A.J. Preparation and characterization of biodegradable magnetic carriers by single emulsion-solvent evaporation. J. Magn. Magn. Mater. 2007, 311, 84–87. [Google Scholar] [CrossRef]
- Das, S.; Suresh, P.K.; Desmukh, R. Design of Eudragit RL 100 nanoparticles by nanoprecipitation method for ocular drug delivery. Nanomed. Nanotechnol. Biol. Med. 2010, 6, 318–323. [Google Scholar] [CrossRef]
- Konan, Y.N.; Cerny, R.; Favet, J.; Berton, M.; Gurny, R.; Allémann, E. Preparation and characterization of sterile sub-200 nm meso-tetra (4-hydroxylphenyl) porphyrin-loaded nanoparticles for photodynamic therapy. Eur. J. Pharm. Biopharm. 2003, 55, 115–124. [Google Scholar] [CrossRef]
- Yehia, S.A.; El-Gazayerly, O.N.; Basalious, E.B. Design and in vitro/in vivo evaluation of novel mucoadhesive buccal discs of an antifungal drug: Relationship between swelling, erosion, and drug release. AAPS Pharm. Sci. Tech. 2008, 9, 1207–1217. [Google Scholar] [CrossRef] [PubMed]
- Wan, L.; Heng, P.; Wong, L. The effect of hydroxypropylmethylcellulose on water penetration into a matrix system. Int. J. Pharm. 1991, 73, 111–116. [Google Scholar] [CrossRef]
- Horwitz, W.; Latimer, G. Official Methods of Analysis of AOAC International 2000; AOAC International: Gaithersburg, MD, USA, 2007. [Google Scholar]
- The National Formulary (NF25), United States Pharmacopeia. 2007, pp. 2748–2751. Available online: https://www.scienceopen.com/document?vid=1ec4a655-58c3-4d61-8906-5c2724f0ea30 (accessed on 7 September 2020).
- Weizhen, C.; Lahu, Y. Outline for British Pharmacopoeia 2011. Chin. Pharm. Aff. 2011, 9. [Google Scholar]
- Dubois, M.; Fluchard, D.; Sior, E.; Delahaut, P. Identification and quantification of five macrolide antibiotics in several tissues, eggs and milk by liquid chromatography–electrospray tandem mass spectrometry. J. Chromatogr. B Biomed. Sci. Appl. 2001, 753, 189–202. [Google Scholar] [CrossRef]
- Solleti, V.S.; Alhariri, M.; Halwani, M.; Omri, A. Antimicrobial properties of liposomal azithromycin for Pseudomonas infections in cystic fibrosis patients. J. Antimicrob. Chemother. 2015, 70, 784–796. [Google Scholar] [CrossRef]
- Salgado, H.; Roncari, A. Microbiological assay for the determination of azithromycin in ophthalmic solutions. Acta Pharmacol. Sin. 2005, 40, 544. [Google Scholar]
- Breier, A.; Garcia, C.; Oppe, T.; Steppe, M.; Schapoval, E. Microbiological assay for azithromycin in pharmaceutical formulations. J. Pharm. Biomed. 2002, 29, 957–961. [Google Scholar] [CrossRef]
- Xu, J.; Li, W.; Liu, Z.; Li, J.; Zhao, X.; Li, D.; Guo, S.; Zhang, X. Preparation, characterization and pharmacokinetics evaluation of clarithromycin-loaded Eudragit® L-100 microspheres. Eur. J. Drug Metab. Pharmacokinet. 2016, 41, 287–293. [Google Scholar] [CrossRef]
- Cetin, M.; Atila, A.; Kadioglu, Y. Formulation and in vitro characterization of Eudragit® L100 and Eudragit® L100-PLGA nanoparticles containing diclofenac sodium. AAPS Pharm. Sci. Tech. 2010, 11, 1250–1256. [Google Scholar] [CrossRef]
- Kempe, H.; Pujolràs, A.P.; Kempe, M. Molecularly imprinted polymer nanocarriers for sustained release of erythromycin. Pharm. Res. 2015, 32, 375–388. [Google Scholar] [CrossRef]
- Cunha-Reis, C.; Machado, A.; Barreiros, L.; Araújo, F.; Nunes, R.; Seabra, V.; Ferreira, D.; Segundo, M.A.; Sarmento, B.; das Neves, J. Nanoparticles-in-film for the combined vaginal delivery of anti-HIV microbicide drugs. J. Control. Release 2016, 243, 43–53. [Google Scholar] [CrossRef]
- Pawar, P.K.; Majumdar, D.K. Effect of formulation factors on in vitro permeation of moxifloxacin from aqueous drops through excised goat, sheep, and buffalo corneas. AAPS Pharm. Sci. Tech. 2006, 7, E89. [Google Scholar] [CrossRef] [PubMed]
- Qaddoumi, M.G.; Gukasyan, H.J.; Davda, J.; Labhasetwar, V.; Kim, K.-J.; Lee, V. Clathrin and caveolin-1 expression in primary pigmented rabbit conjunctival epithelial cells: Role in PLGA nanoparticle endocytosis. Mol. Vis. 2003, 9, 559–568. [Google Scholar]
- Morsi, N.; Ghorab, D.; Refai, H.; Teba, H. Ketoroloac tromethamine loaded nanodispersion incorporated into thermosensitive in situ gel for prolonged ocular delivery. Int. J. Pharm. 2016, 506, 57–67. [Google Scholar] [CrossRef] [PubMed]
- Zuckerman, J.M. Macrolides and ketolides: Azithromycin, clarithromycin, telithromycin. Infect. Dis. Clin. N. Am. 2004, 18, 621. [Google Scholar] [CrossRef] [PubMed]
- Ali, A.B.; Goldstein, F.W.; Acar, J.F. In vitro activity of macrolides against traditional susceptible bacteria. In Macrolide Antibiotics; Springer: Basel, Switzerland, 2002; pp. 185–200. [Google Scholar]

| Formulation | Eudragit (mg/mL) | PVA (mg/mL) | Drug: Eudragit (%W/W) | Particle Size (nm) | Polydispersity Index | Zeta Potential (mV) | EE * (%) |
|---|---|---|---|---|---|---|---|
| AZM-NP-1 | 2.5 | 10 | 10 | 38.5 ± 2.3 | 0.222 ± 0.003 | −3.58 ± 0.90 | 32.14 ± 0.09 |
| AZM-NP-2 | 5 | 10 | 10 | 53.4 ± 3.7 | 0.198 ± 0.005 | −3.7 ± 2.30 | 46.30 ± 0.12 |
| AZM-NP-3 | 10 | 2.5 | 10 | 97.2 ± 4.3 | 0.232 ± 0.009 | −6.07 ± 1.02 | 52.29 ± 0.32 |
| AZM-NP-4 | 10 | 5 | 10 | 81.7 ± 5.1 | 0.209 ± 0.003 | −3.32 ± 1.60 | 55.06 ± 0.24 |
| AZM-NP-5 | 10 | 10 | 10 | 78.0 ± 2.3 | 0.179 ± 0.007 | −2.45 ± 0.69 | 62.16 ± 0.07 |
| Formulation | Eudragit (mg/mL) | PVA (mg/mL) | Drug: Eudragit (%) | HEC (mg/mL) | HPMC (mg/mL) |
|---|---|---|---|---|---|
| AZM film—HEC | 10 | 10 | 10 | 0.66 | - |
| AZM film—HPMC | 10 | 10 | 10 | - | 0.66 |
| Formulation | Thickness (mm) | Folding Endurance | Moisture Absorption (%) | Moisture Loss (%) | Swelling (%) | Elongation at Break (%) | Tensile Strength (MPa) | pH (Mean ± SD) |
|---|---|---|---|---|---|---|---|---|
| AZM film-HPMC | 0.164 ± 0.005 | 202.0 ± 6.6 | 3.9 ± 0.4 | 1.4 ± 0.2 | 207.5 ± 4.1 | 4.4 ± 0.3 | 22.6 ± 5.2 | 6.6 ± 0.1 |
| AZM film-HEC | 0.156 ± 0.008 | 267.6 ± 8.0 | 5.0 ± 0.7 | 1.5 ± 0.3 | 231.7 ± 0.6 | 5.1 ± 0.3 | 26.7 ± 3.6 | 6.8 ± 0.1 |
| Kinetic Models | HPMC Film/RSQ * | HEC Film/RSQ * |
|---|---|---|
| Zero | 0.988 | 0.972 |
| first | 0.984 | 0.983 |
| Higuchi | 0.920 | 0.962 |
| Peppas | 0.985 | 0.948 |
Publisher’s Note: MDPI stays neutral with regard to jurisdictional claims in published maps and institutional affiliations. |
© 2020 by the authors. Licensee MDPI, Basel, Switzerland. This article is an open access article distributed under the terms and conditions of the Creative Commons Attribution (CC BY) license (http://creativecommons.org/licenses/by/4.0/).
Share and Cite
Taghe, S.; Mirzaeei, S.; Alany, R.G.; Nokhodchi, A. Polymeric Inserts Containing Eudragit® L100 Nanoparticle for Improved Ocular Delivery of Azithromycin. Biomedicines 2020, 8, 466. https://doi.org/10.3390/biomedicines8110466
Taghe S, Mirzaeei S, Alany RG, Nokhodchi A. Polymeric Inserts Containing Eudragit® L100 Nanoparticle for Improved Ocular Delivery of Azithromycin. Biomedicines. 2020; 8(11):466. https://doi.org/10.3390/biomedicines8110466
Chicago/Turabian StyleTaghe, Shiva, Shahla Mirzaeei, Raid G. Alany, and Ali Nokhodchi. 2020. "Polymeric Inserts Containing Eudragit® L100 Nanoparticle for Improved Ocular Delivery of Azithromycin" Biomedicines 8, no. 11: 466. https://doi.org/10.3390/biomedicines8110466
APA StyleTaghe, S., Mirzaeei, S., Alany, R. G., & Nokhodchi, A. (2020). Polymeric Inserts Containing Eudragit® L100 Nanoparticle for Improved Ocular Delivery of Azithromycin. Biomedicines, 8(11), 466. https://doi.org/10.3390/biomedicines8110466







